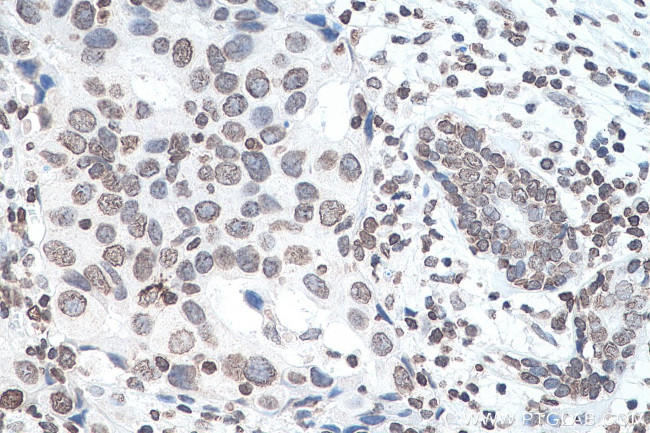
m6A Antibody in Immunohistochemistry (Paraffin) (IHC (P))

Search
Proteintech
m6A Monoclonal Antibody (1D5E10)
{{$productOrderCtrl.translations['antibody.pdp.commerceCard.promotion.promotions']}}
{{$productOrderCtrl.translations['antibody.pdp.commerceCard.promotion.viewpromo']}}
{{$productOrderCtrl.translations['antibody.pdp.commerceCard.promotion.promocode']}}: {{promo.promoCode}} {{promo.promoTitle}} {{promo.promoDescription}}. {{$productOrderCtrl.translations['antibody.pdp.commerceCard.promotion.learnmore']}}
产品信息
68055-1-IG150UL
种属反应
宿主/亚型
分类
类型
克隆号
偶联物
形式
浓度
规格
纯化类型
保存液
内含物
保存条件
运输条件
靶标信息
N6-methyladenosine (m6A), or methylation of the N6 position of adenosine is a posttranscriptional modification of RNA. Due to a lack of analytical methods, N6-methyladenosine is poorly understood, but new evidence suggests that it is a very common base modification and important physiological regulator. N6-methyladenosine is markedly increased throughout brain development, and is enriched near stop codons, microRNA-binding sites and UTRs, which indicates a fundamental role in the regulation of gene expression. N6-methyladenosine is also highly conserved between human and mouse.
仅用于科研。不用于诊断过程。未经明确授权不得转售。
篇参考文献 (0)
生物信息学
蛋白别名: C11H15N5O4; m6A